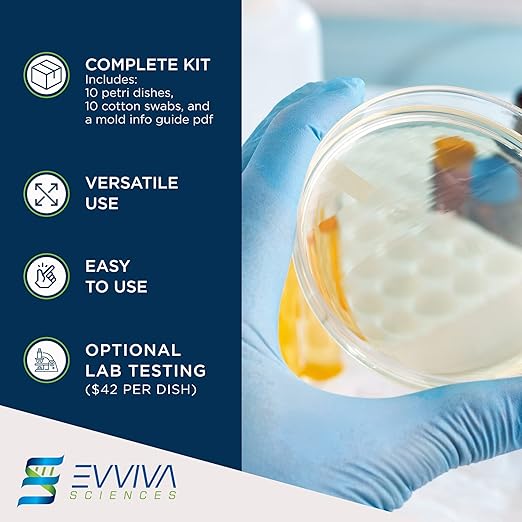

EVVIVASCIENCES
Evviva Sciences Mold Test Kit for Home - 10 Easy Detection Tests w/Optional Lab Analysis (Extra Fee), Test HVAC System, Surfaces, & Indoor Air Quality Testing Kit - Downloadable Mold Information Guide
Evviva Sciences Mold Test Kit for Home - 10 Easy Detection Tests w/Optional Lab Analysis (Extra Fee), Test HVAC System, Surfaces, & Indoor Air Quality Testing Kit - Downloadable Mold Information Guide
Couldn't load pickup availability
About This
- 10 SEPARATE TESTS: The Evviva Sciences Mold Testing Kit comes with 10 agar petri dishes, 10 cotton-tipped swabs, a detailed mold information guide (pdf), and an optional lab analysis (for an additional fee of $45 per dish). The agar petri dishes allow for easy and accurate collection of mold samples, the cotton-tipped swabs are useful for quick tests to detect surface molds, and the information guide pdf provides detailed information about different types of molds.
- TEST ROOM AIR, HVAC SYSTEM, & ANY HOUSEHOLD SURFACE: This air mold test kit is a tool that helps to determine the amount of mold in indoor air. It tests for a wide range of molds, including common household varieties. Perform tests in 10 different parts of home or office, such as the walls, shower, car, sink, HVAC system, room air, and other physical surfaces.
- OPTIONAL LAB TEST AVAILABLE (EXTRA FEE REQUIRED): Our kit comes with an optional mold identification lab test from an AIHA certified laboratory. There are two different laboratory options to choose from, but each requires an extra fee of ~$45 per dish. The lab test provides a detailed identification report about the types of molds from your test. For a complete assessment of your home, consider ordering the lab analysis.
- MOLD INFORMATION GUIDE PDF: The kit comes with a downloadable guide with multiple images, and information about common household molds. Our guide has pictures of common molds, but mold identification usually requires a lab test. Our guide can be extremely helpful to learn about the risks of certain mold types and how to reduce contamination in your home.
- DISCOVER HOUSEHOLD MOLDS: Test room air, HVAC system, and any household surface in depth. This air mold test kit is designed for home or office use. It is an efficient air mold test kit, and you will see results in as little as 2-4 days. Get five samples from various places and analyze the levels of different molds to assess the environmental situation of your home.